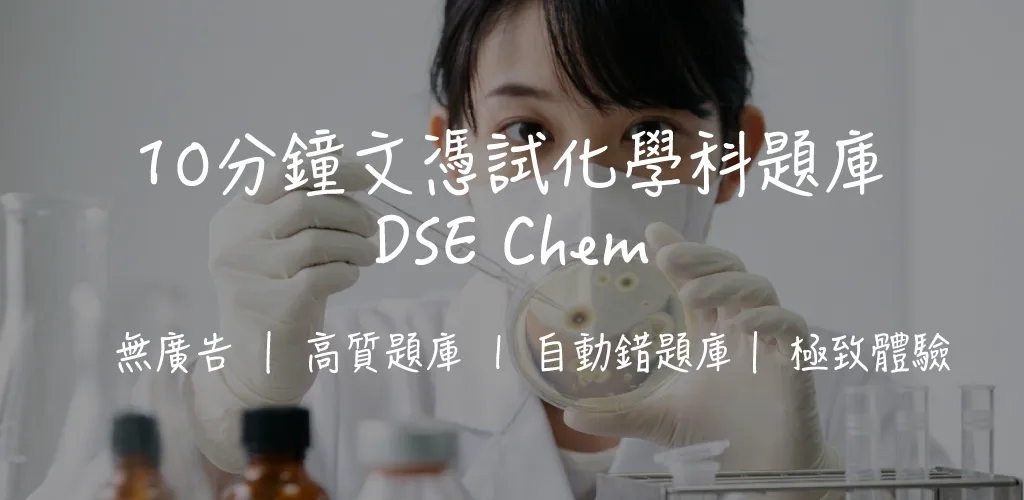
DSE 化學科完全攻略:十二大必修課題 + 選修單元全面解析 | 考試形式、溫習策略與高頻考點

專為 CRE 英文運用測試而設
涵蓋語法、閱讀理解、錯誤辨認及句子填充,每個功能都針對 CRE 英文運用核心考點設計。
無干擾學習環境
堅持零廣告政策,讓你全心投入在英文題目練習中。清爽的介面設計,讓溫習英文不再是壓力。
高質量模擬題庫
題目難度與題型緊扣官方考試要求。每一道題都配備詳細解析,助你找出文法弱點,徹底理解錯誤原因。
碎片時間高效利用
無論是在地鐵還是休息時間,隨時隨地開啟練習模式。智能排題助你有效分配溫習進度。
實時查看全港回答分佈率
想知道哪一題是大家的「陷阱題」?系統實時統計全港考生的解答數據,讓你在作答後立即對照大眾選擇,精準避開常見錯誤。
- 掌握全港考生答題趨勢
- 一眼識破高難度陷阱題
- 統計數據每日自動更新
The committee has decided to _______ the proposal until further notice.
62% 的考生選擇了正確答案
基於真實考生回饋編寫題目
我們不只是掃讀原文。題庫會根據大量考生考後的真實回饋(Feedback)不斷迭代。我們將精華轉化為模擬題目,讓你面對考試時更有似曾相識的熟悉感。
聲明:所有題目均為基於回饋而原創之模擬題目,並非真實試題。
- 捕捉考法精髓與命題邏輯
- 定期優化題目描述與選項
- 強調:純屬模擬,助你掌握概念
* 根據考生反饋原創的模擬題目
每日 10 分鐘,勝過死記 1 小時
透過智能排題與精選題目。你不再需要盲目背誦,而是把有限的精力全部鎖定在最高回報率的「得分位」上。
- 利用碎片時間完成系統學習
- 考前無需抱佛腳,記憶早已穩固
* 投資回報率 (ROI) 以每分鐘學習的回憶概率定義
錯題重溫與重點書籤
自動記錄你的答錯題目,並支持為重點難點打上書籤。考前只需集中溫習標記內容及錯題,複習效率提升 3 倍。
- 自動追蹤弱項,對症下藥
- 書籤功能,鎖定核心考點
- 利用碎片時間快速重溫
為什麼選擇 10minquiz?
簡單比較,清晰選擇
題目數量
題目質量
更新頻率
原文解釋
模擬考試
使用便利性
錯題重溫
| 功能特點 | 10minquiz 推薦 | 其他App | 傳統/紙本 |
|---|---|---|---|
| 題目數量 | 1200+貼近真題 | 通常少於200題 | 因篇幅受限 |
| 題目質量 | 質量接近考試 | 通常只有3個選項 | 難以接近考試 |
| 更新頻率 | 每星期更新 | 少量更新 | 需重新購買 |
| 原文解釋 | 詳細對照 | 沒有提供 | 少有提供 |
| 模擬考試 | 完整模擬 | 基礎模擬 | 無法模擬 |
| 使用便利性 | 極致簡潔 | 複雜混亂 | 攜帶不便 |
| 錯題重溫 | 智能記錄 | 少有提供 | 需手動記錄 |
備考攻略
掌握最新考試資訊
常見問題
關於 CRE 英文運用測試的常見疑問
英文運用測試為多項選擇題形式,考試時間為 45 分鐘。試題涵蓋 Grammar(語法)、Reading Comprehension(閱讀理解)、Error Identification(錯誤辨認)及 Sentence Completion(句子填充)等核心範疇。成績分為二級(Higher)及一級(Lower)。
CRE 英文運用是專為公務員招聘設計的語文能力測試,全部為多項選擇題,著重測試語法精確度、閱讀理解及錯誤辨認能力。不設寫作、聆聽或口語部分。相比 IELTS 或 DSE,CRE 更側重語法細節和公務英語理解。
一般而言,具備 DSE English Level 3 或以上水平即有基礎應付 CRE 英文運用。但由於 CRE 著重語法精確度和錯誤辨認,建議針對性溫習常見語法考點,如 subject-verb agreement、tense consistency、preposition usage 等。
CRE 英文運用測試的成績永久有效。一旦取得二級成績,日後申請不同政府職位時均可使用,無需重考。但如只取得一級而目標職位要求二級,可選擇再次應考。
基本功能完全免費,您可以免費練習大部分題目。我們亦提供 Pro 功能,解鎖完整 1200+ 題庫、100% 無廣告體驗及詳細學習分析報告,助你更有效率地備考 CRE 英文運用測試。